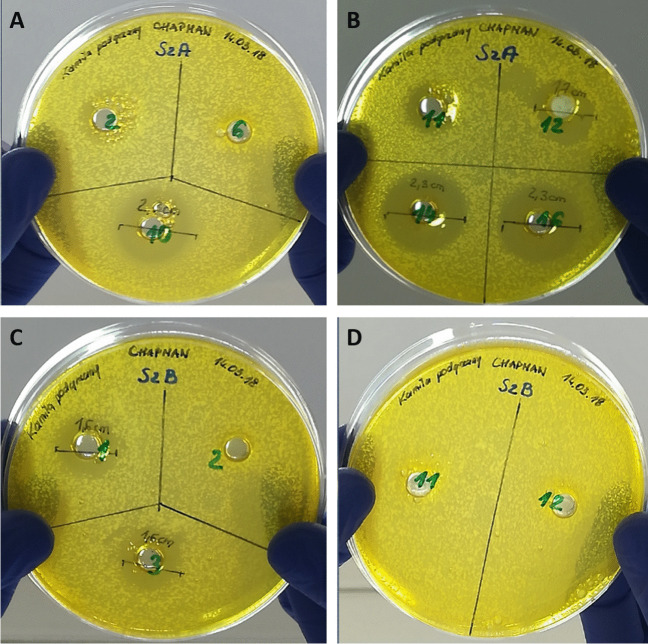
Fig. 1

Abstract
Abstract
The aim of this study was the whole-genome analysis and assessment of the antimicrobial potential of bacterial isolates from honey harvested in one geographical location—the north of Poland. In total, 132 strains were derived from three honey samples, and the antimicrobial activity of CFAM (cell-free after-culture medium) was used as a criterion for strain selection and detailed genomic investigation. Two of the tested isolates (SZA14 and SZA16) were classified as Bacillus paralicheniformis, and one isolate (SZB3) as Bacillus subtilis based on their ANI and phylogenetic analysis relatedness. The isolates SZA14 and SZA16 were harvested from the same honey sample with a nucleotide identity of 98.96%. All three isolates have been found to be potential producers of different antimicrobial compounds. The secondary metabolite genome mining pipeline (antiSMASH) identified 14 gene cluster coding for non-ribosomal peptide synthetases (NRPs), polyketide synthases (PKSs), and ribosomally synthesized and post-translationally modified peptides (RiPPs) that are potential sources of novel antibacterials. The BAGEL4 analysis revealed the presence of nine putative gene clusters of interest in the isolates SZA14 and SZA16 (including the presence of six similar clusters present in both isolates, coding for the production of enterocin Nkr-5-3B, haloduracin-alpha, sonorensin, bottromycin, comX2, and lasso peptide), and four in B. subtilis isolate SZB3 (competence factor, sporulation-killing factor, subtilosin A, and sactipeptides). The outcomes of this study confirm that honey-derived Bacillus spp. strains can be considered potential producers of a broad spectrum of antimicrobial agents.
Key points
• Bacteria of the genus Bacillus are an important component of honey microbiota.
• Honey-derived Bacillus spp. strains are potential producers of new antimicrobials.
Supplementary Information
The online version contains supplementary material available at 10.1007/s00253-023-12732-9.
Keywords: Honey, Whole-genome sequencing, Bacillus spp., Antimicrobial peptides
Introduction
Bee products such as honey and propolis have been frequently used as traditional remedies since ancient times (Waddington 1991). It has been used by the Egyptians, Romans, Greeks, and Chinese for centuries for healing wounds, gut diseases, gastric ulcers, coughs, and sore throats (Al-Jabri 2013). Natural honey is a mixture of carbohydrates (82.4%), fructose (38.5%), glucose (31%), other sugars (12.9%), water (17.1%), protein (0.5%), and several minerals, vitamins, amino acids, and phenols, as well as traces of bioactive components such as phenolic acid, flavonoids, and α-tocopherol (Pasupuleti et al. 2017). The health benefits of honey are attributed to its constituents, which include phenolic acids, flavonoids, ascorbic acid, proteins, carotenoids, and certain enzymes such as glucose oxidase and catalase (Moniruzzaman et al. 2011). The wide range of antimicrobial activity of honey is due to various components contributing to its antibacterial potential: the sugar content, polyphenol compounds, hydrogen peroxide, 1,2-dicarbonyl compounds, and bee defensin-1 (Almasaudi 2021).
Raw honey is a reservoir for several microbial species like mold, yeast, and spore-forming bacteria (Snowdon and Cliver 1996). The bees collect nectar and pollen at a distance up to 2 km from the hive, which results in a high diversity of microorganisms in these “raw materials” (Brudzynski 2021). However, the diversity and composition of raw product microbiota change significantly as a result of the transformation of nectar to honey and bee pollen to bee bread. The majority of bacteria (including pathogenic species) are eliminated as a result of water evaporation (increased sugar concentration), acidification, and the presence of bee-derived antimicrobial compounds, e.g., bee defensin-1 and glucose oxidase and also antagonistic or competitive microbe-microbe interactions (Brudzynski 2021). Although the composition of the microbiota in bee products might differ with respect to botanical and geographical origins, the keystone species in the core microbiota of honey and bee bread are Bacillus and Lactobacillus (Grabowski and Klein 2017; Brudzynski 2021). Recent studies have shown that most of the LAB and Bacillus species, including Lactobacillus casei, Lactobacillus plantarum, B. subtilis, and B. velezensis, have been shown to exhibit antibacterial and antifungal activity and are promising sources of novel antimicrobials (Schnürer and Magnusson 2005; Lee et al. 2008b, a; Pajor et al. 2018; Wadi 2022; Xiong et al. 2022). Bacillus species are ubiquitous and survive in complex, competitive microbial communities like soil and the ocean (Harwood et al. 2018). Therefore, a large portion of their genome undergoes secondary metabolism and synthesizes diverse secondary metabolites exhibiting broad-spectrum antimicrobial activity (Motta et al. 2008; Li et al. 2012; Sabaté and Audisio 2013). Moreover, due to their spore-forming ability, they can withstand the harsh conditions of honey.
To date, the majority of microbial strains producing efficient antibiotics are recovered from soil (Newman and Cragg 2007). Several research groups, including ours, have recently revealed that honey (Lee et al. 2008b; Pajor et al. 2018, 2020; Xiong et al. 2022) and other bee products, such as bee pollen or bee bread (Didaras et al. 2020; Pełka et al. 2021a, b), can be considered a reservoir of microbes producing metabolites with antibacterial and antifungal potential. A majority of isolates derived from bee products exhibit antimicrobial (antibacterial and/or antifungal) potential (Lee et al. 2008b; Pajor et al. 2018; Pełka et al. 2021b), which is an important benefit of this reservoir. Both Bacillus and Lactobacillus are well-known producers of a broad spectrum of antimicrobial compounds, including antibiotics, bacteriocins, and biosurfactants (Zacharof and Lovitt 2012; Sumi et al. 2015). In this study, we performed whole-genome sequencing analysis and screening of secondary metabolites of Bacillus isolates to provide a better understanding of the molecular mechanism for this adaptation that might lead to the discovery of new antibacterial compounds.
Methodology
Honey samples and isolation of bacterial strains
The three samples of multi-flower honey (SZA, SZB, and SZC) were collected from two apiaries located in the Sulmin village (Pomeranian Voivodeship; North of Poland) on June 20, 2018, and the strains were isolated in October 2018. The honey samples were stored in the dark at ambient temperature. The isolation of bacterial isolates and determination of their antibacterial potential were performed according to the methodology presented in our previous publication (Pajor et al. 2018), with slight modifications. Briefly, the honey samples were diluted in sterile distilled water in a 1:1 (v/v) ratio, and 1 ml of each suspension was streaked on a Petri dish (φ = 200 mm) containing solid growth medium (Luria–Bertani—LB agar). The Petri dishes were then incubated overnight at 37 °C, and the growing colonies were counted.
Determination of antimicrobial potential (ability to produce antimicrobial metabolites) was performed by the transfer of selected colonies of bacteria with a sterile pipette tip on the surface of LB agar medium (in the form of about 10-mm-long lines) inoculated with Staphylococcus aureus ATCC 25923 or S. aureus ATCC 29213 strains. The pre-inoculation was performed by streaking S. aureus (the final optical density of each suspension was OD600 = 0.1) reference strains with a sterile cotton swab soaked in a suspension. Thereafter, the growth inhibition zones of S. aureus ATCC 25923 and S. aureus ATCC 29213 near the lines of the growing cells of the isolated bacteria were observed.
Furthermore, the selection of the most promising producing strains (PS—isolates that exhibited abilities to produce antimicrobial compounds) was performed by growing bacteria in the liquid (LB broth) medium and determining the presence of the active compounds in the cell-free after-culture medium (CFAM). The isolates were grown for 18–24 h (37 °C with shaking at 180 rpm). The CFAM was obtained by centrifugation (12,000 rpm, 15 min) and heat treatment of the supernatant (60 °C, for 10 min). A total of 50 µl of the CFAM was loaded into the wells on the Chapman agar plates, which were already inoculated with the S. aureus reference strain. The plates were incubated for 18–24 h at 37 °C and growth inhibition zones were observed and measured.
DNA isolation and sequencing
Isolation and sequencing of bacterial genomic DNA were performed in the DNA Sequencing and Oligonucleotide Synthesis Laboratory of the Institute of Biochemistry and Biophysics, Polish Academy of Science (Warsaw, Poland). Cell pellets from the overnight LB culture of the isolates were treated with the CTAB/lysozyme method and the template DNA quality and quantity were checked on the agarose gel. Genomic bacterial DNA was mechanically sheared to an appropriate size for Paired-End TruSeq-like library construction using the KAPA Library Preparation Kit (KAPA/Roche, Basel, Switzerland) following the manufacturer’s instructions. The bacterial genomes were sequenced in paired-end mode (v3, 600 cycle chemistry kit) using MiSeq (Illumina, San Diego, CA).
A quality check for raw reads was performed with FASTQC and reads were trimmed and paired using Trimmomatic (version 0.38.0) (Bolger et al. 2014) with the following parameters: LEADING: 3 TRAILING: 3 SLIDINGWINDOW: 4:20 MINLEN: 25. A secondary read quality check was performed after trimming to ensure normal results for “per base sequence quality,” “per base N content,” “sequence duplication levels,” and “adapter content.” De novo assembly was performed with Unicycler (version 0.4.8.0) (Wick et al. 2017) using default k-mer settings for bacterial genome assembly. Scaffolds less than 500 bp were removed and assembly statistics [e.g., number of contigs, N50 (widely used to assess the contiguity of an assembly), G + C content] were assessed using QUAST (Version 5.0.2) (Gurevich et al. 2013). The resulting final assembly files were BLASTed in the National Center for Biotechnology Information (NCBI) and the genome assemblies of closely related group-type strains were downloaded from the assembly database. Average nucleotide identity (ANI) of the isolates was calculated with the OrthoANI method using OAT (version 0.93.1) and BLAST + (version 2.13.0) (Lee et al. 2016). Rapid genome annotation was performed using Prokka (version 1.14.6) (Seemann 2014). Additional genome annotation was performed with the NCBI Prokaryotic Genome Annotation Pipeline (PGAP) (https://github.com/ncbi/pgap) on a local machine (Tatusova et al. 2016). Assembled genomes of B. paralicheniformis_SZA14, B. paralichenifromis_SZA16, and B. subtilis_SZB3 were submitted to Sequence Read Archive (SRA) and GenBank under the BioProject IDs PRJNA925310, PRJNA926019 and PRJNA926020, respectively. SRA accession numbers for B. paralicheniformis_SZA14, B. paralicheniformis_SZA16, and B. subtilis_SZB3 are SRR23118077, SRR23175314, and SRR2315315, respectively. Moreover, the selected strains were deposited to the German Collection of Microorganisms and Cell Cultures (DSMZ, https://www.dsmz.de/collection/deposit/open-collection/microorganisms) under the numbers DSM 115813; B. paralicheniformis_SZA14, DSM 115814; B. paralicheniformis_SZA16 and DSM 115815; B. subtilis_SZB3. The functional annotations were carried out using the eggNOG mapper v2 (http://eggnog-mapper.embl.de/) (Cantalapiedra et al. 2021).
Whole-genome-based phylogenetic analysis
The whole-genome-based taxonomic analysis was performed by the Type (strain) Genome Server (TYGS) (https://tygs.dsmz.De) (Meier-Kolthoff 2019). The draft genomes of isolates SZA14, SZA16 and SZB3 sequenced in this study and 17 other closely related genomes of the B. paralicheniformis and B. subtilis groups, as well as the complete genome of Bacillus capparidis strain DSM103394 as an outgroup, were extracted from NCBI (accession numbers Supplementary Table S1) and submitted to the TYGS server, settings: restricted genome mode. A phylogenomic tree was constructed with FastME (based on balanced minimum evolution and renders distance algorithms to infer phylogenies) (Lefort et al. 2015) using the genome blast distance phylogeny (GBDP) method and annotated using Interactive Tree of Life (iTOL) v5, an online tool for phylogenetic tree display and annotation (Letunic and Bork 2021). All pair-wise genome comparisons were carried out with GBDP and inter-genomic distances inferred under the algorithm “trimming” and distance formula d5 (Meier-Kolthoff 2019). The tree was rooted at the midpoint (Farris 1972). Branch supports were inferred from 100 pseudo-bootstrap replicates.
Core SNP–based phylogeny
For further validation, a single nucleotide polymorphism (SNP)–based tree was constructed using the program kSNP v4.0. The optimal k-mer size of 17 was determined using the Kchooser module of kSNP v4.0 (Gardner and Hall 2013). The phylogenetic analysis was performed with core SNPs using a Bayesian approach as implemented in MrBayes version 3.2.6 (available on http://www.phylogeny.fr/one_task.cgi?task_type=mrbayes) (Ronquist et al. 2012). Under the likelihood model, the substitution types were set to General Time-Reversible 6 (GTR), the substitution model was kept as the default, and variation rates across sites were selected as invariable + gamma. Markov chain Monte Carlo parameters, i.e., the number of generations, were 100,000. The tree was sampled every 1000 generations and the first 100 trees sampled were discarded. The tree was inferred with iTOL v5 (Letunic and Bork 2021).
A broad analysis of the genomes using genome mining tools
The genomes of isolates SZA14, SZA16, and SZB3 were compared to the respective type strain with Mauve (v20150226) using progressive alignment and seed-families options (Darling et al. 2004). The secondary metabolite genome mining pipeline (antiSMASH), with parameter strict, was used for the identification of gene clusters coding for potential secondary metabolites (Blin et al. 2021). Putative bacteriocin genes were detected with BAGEL4 (Van Heel et al. 2018). The web server Prophage hunter was employed for rapid identification and annotation of prophage sequences within bacterial genomes (Song et al. 2019).
Functional annotation of the carbohydrate-active enzyme (CAZyme)
Accurate functional annotation of the proteome is the cornerstone of a successful genomics project. Different carbohydrate-active enzymes (CAZymes) were annotated by the dbCAN database (https://bcb.unl.edu/dbCAN2/index.php), a Meta server for automated carbohydrate-active enzyme annotation which were then summarized after manual curation and prospected using the Enzyme Commission (EC) number (Zhang et al. 2018). The biotechnological applications were determined by the list of the Association of Manufacturers and Formulators of Enzyme Products (AMFEP) and BRENDA database (http://www.brenda-enzymes.org/) (Placzek et al. 2017).
Identification of antimicrobial peptides
For the detection of peptides with antimicrobial potential, online antimicrobial peptide database servers AMPA (https://tcofee.crg.cat/apps/ampa/do) (Torrent et al. 2012), ADAM (https://bioinformatics.cs.ntou.edu.tw/ADAM/) (Lee et al. 2015) and CAMPR4 (http://www.camp.bicnirrh.res.in/) (Waghu et al. 2016) were used. Commonly predicted peptides with lengths between 5 and 150 residues were analyzed sequentially in the APD3 database. The criteria for a positive conclusion for possible antimicrobial activity prediction in AMPA, ADAM, and CAMPR3 were defined as > 0.15 in AMPA, > 1 in ADAM, and > 0.5 in CAMPR3 (Pavlova et al. 2020).
Results
Strain selection
Considering the level of microbial contamination of the honey samples, some important differences were observed. The highest number of colonies (n = 116) was grown on the plate inoculated with the suspension of honey A, while only 12 and 4 colonies were grown on the plates that were inoculated with honey samples B and C, respectively.
The screening for the production of antimicrobial compounds was performed on randomly selected 20, 10, and 3 colonies recovered from honey samples A, B, and C, respectively. Anti-staphylococcal activity and the presence of Staphylococci growth inhibition zones around the colonies of bacterial isolates were identified for 7 out of 20 isolates from product A (35%), 5 out of 10 (50%) from product B, and 2 out of 3 (66%) from product C. However, further analysis confirmed the presence of antimicrobial metabolites in the CFAM for 7 strains isolated from sample A, 2 strains isolated from sample B, and none from sample C.
The bacterial isolates from the sample, SZA14, SZA16, and SZB3 (Fig. 1), were potentially the best producers of antimicrobials and were selected for whole-genome sequencing, aiming to identify the genes responsible for the synthesis of antimicrobial compounds.
Fig. 1.
Anti-staphylococcal activity of CFAM (cell-free after-culture medium) of selected strains isolated from honey SZA (A and B) and SZB (C and D)
Whole-genome sequencing and genome analysis
The 4,507,369 bp genome of isolate SZA14 was assembled into 46 contigs with a GC content of 45.59% and an N50 of 276,250 bp (Supplementary Table S2, Quast report). The 4,379,317 bp genome of isolate SZA16 was assembled into 21 contigs with a GC content of 45.81% and an N50 of 668,104 bp (Supplementary Table S2, Quast report). The genome of isolate SZB3 (4,244,057 bp) was assembled into 19 contigs with a GC content of 43.42% and an N50 of 2,257,132 (Supplementary Table S2, Quast report). Isolate SZA14 contained an estimated 4627 genes and 4541 coding sequences (CDSs), 86 RNAs, 3 rRNAs (5S, 16S, and 23S), and 78 tRNAs. Isolate SzA16 consisted of an estimated 4439 genes, 4352 CDSs, 87 RNAs, 3 rRNAs (5S, 16S, and 23S), and 79 tRNAs. On the other hand, isolate SZB3 had 4489, 4408 CDSs, 81 RNAs, 3 rRNAs (5S, 16S, and 23S), and 73 tRNA.
Average nucleotide identity (ANI) classified the isolates at the species level. Isolates SZA14 and SZA16 were most closely related to type strains B. paralicheniformis HAS-1 and B. paralicheniformis FA6, with orthoANI values of 99.36% and 99.98%, respectively. Isolate SZB3 was closely related to B. subtilis strain P9B1 with an orthoANI value of 99.96% (Table 1). The ANI between isolates SZA14 and SZA16 was 98.96%. Based on the proposed species boundary of 95–96% orthoANI value, SZA14 and SZA16 were classified as B. paralicheniformis species and SZB3 as B. subtilis specie (Goris et al. 2007; Richter and Rosselló-Móra 2009).
Table 1.
Average nucleotide identity (ANI) calculated by OAT with BLAST +
| Query genome | Reference genome | OrthoANI value (%) |
|---|---|---|
| Isolate SZA14 | Bacillus paralicheniformis_StrainHAS-1 | 99.3641 |
| Isolate SZA14 | Bacillus paralicheniformis_StrainTXO7B-1SG6 | 99.2902 |
| Isolate SZA14 | Bacillus paralicheniformis_StrainBL-09 | 98.9642 |
| Isolate SZA14 | Bacillus paralicheniformis_StrainNCTC8721 | 99.2516 |
| Isolate SZA16 | Bacillus paralicheniformis_FA6 | 99.9764 |
| Isolate SZA16 | Bacillus paralicheniformis_StrainCBMAI1303 | 99.9734 |
| Isolate SZA16 | Bacillus paralicheniformis_StrainJ36TS2 | 99.9504 |
| Isolate SZA16 | Bacillus paralicheniformis_ATCC9945a | 99.9586 |
| Isolate SZB3 | Bacillus subtilis_StrainP9_B1 | 99.9623 |
| Isolate SZB3 | Bacillus subtilis_StrainBsi | 99.8094 |
| Isolate SZB3 | Bacillus subtilis_StrainFJAT-4 | 99.841 |
| Isolate SZB3 | Bacillus subtilis_StrainP8_B3 | 99.8312 |
Phylogenetic analysis
To elucidate the phylogenetic relationships between our isolates and the closely related Bacillus species, a total of 17 genomes were downloaded from the NCBI database. Nine B. paralicheniformis group isolates, seven B. subtilis isolates, and one B. capparidis strain DSM103394 as an outgroup were included in the phylogenetic analysis. The phylogenetic tree based on the SNPs and the entire genome revealed that the isolates from this study have close relatedness to the type strains B. paralicheniformis (isolates SZA14 and SZA16) and B. subtilis (strain SZB3) (Fig. 2).
Fig. 2.
A Core SNP–based Bayesian phylogenetic tree inferred by MrBayes. The branch structure was confirmed by a bootstrap consensus tree inferred from 1000 replicates and annotated in iTOL. B Genome tree inferred with FastME 2.1.6.1 (Lefort et al. 2015) from GBDP distances calculated from genome sequences. The branch lengths are scaled in terms of the GBDP distance formula d5. The numbers above branches are GBDP pseudo-bootstrap support values > 60% from 100 replications, with an average branch support of 21.2%. The tree was rooted at the midpoint (Farris 1972). The trees were finally imported to Adobe Illustrator for refinement
Functional prediction
Clusters of orthologous groups (COG) functional group analysis was performed using eggNOG mapper v2. For the isolate SZA14, 4105 genes out of 4462 (91%) were assigned to 21 clusters (Fig. 3). The Function unknown (S: 1075) category had the highest numbers, implicating the uniqueness and yet-to-explore potential of this isolate. The remaining proteins were categorized under functional groups such as transcription (K: 347); amino acid transport and metabolism (E: 270); carbohydrate transport and metabolism (G: 251); inorganic ion transport and metabolism (P: 206); energy production and conversion (C: 184); translation, ribosomal structure and biogenesis (J: 183); cell wall/membrane/envelope biogenesis (M: 182); replication, recombination and repair (L: 146); coenzyme transport and metabolism (H: 116); nucleotide transport and metabolism (F: 107); signal transduction mechanisms (T: 107); posttranslational modification, protein turnover, chaperones (O: 91); lipid transport and metabolism (I: 80); defense mechanisms (V: 72); chromosome partitioning (D: 48); cell cycle control, cell division, secondary metabolites biosynthesis, transport and catabolism (Q: 47); cell motility (N: 34) intracellular trafficking, secretion, and vesicular transport (U: 34); and RNA processing and modification (A: 2) (Fig. 3a). 4026 entries out of 4270 (94%) for strain SZA16 were classified into 21 different COG categories (3b) and for SZB3 3976 out of 4348 entries (91%) were assigned to 21 different COG categories (3c).
Fig. 3.
Distribution of Cluster of Orthologous group (COG) functional categories to the proteins of isolate a SZA14; b SZA16; c SZB3. The X-axis denotes the number of protein and Y-axis denotes COG categories. Each alphabet represents a unique COG category. A—RNA processing and modification; C denotes energy production and conversion; D—cell cycle control, cell division, and chromosome partitioning; E—amino acid transport and metabolism; F—nucleotide transport and metabolism; G—carbohydrate transport and metabolism; H—coenzyme transport and metabolism; I—lipid transport and metabolism; J—translation, ribosomal structure, and biogenesis; K—transcription; L—replication, recombination, and repair; cell wall/membrane/envelope biogenesis; N—cell motility; O—posttranslational modification, protein turnover, chaperones; P—inorganic ion transport and metabolism; Q—secondary metabolite biosynthesis, transport, and catabolism; S—function unknown; T—signal transduction mechanisms; U—intracellular trafficking, secretion, and vesicular transport; and V—defense mechanisms
BRIG and secondary metabolite analysis
Additional genome comparisons of B. paralicheniformis type strains and B. subtilis strains and isolates SZA14, SZA16, and SZB3 were visualized with BRIG version 0.95. The diagrammatic representation of SZA16 is represented in Fig. 4, while that of SZA14 and SZB3 is represented in (Supplementary Figures S1a and S1b). Gaps in the circular chromosome represented regions with no homology to the reference strains. Gaps for the isolates in our study were consistent due to high levels of nucleotide homology. Gaps at several positions observed when comparing isolates from this study with the closely related Bacillus strains indicated the potential presence of novel gene products. When visualized with Mauve, divergent regions and genetic rearrangement were observed, indicating the presence of mobile genetic elements (plasmids, prophages, and transposons) within each genome, specifically prophages.
Fig. 4.
Genome comparison of B. paralicheniformis_SZA16 against closely related Bacillus type strains, B. paralicheniformis_strainFA6, and B. paralicheniformis_strainCBMAI1303. From the inner to the outer ring: (1) GC Content, black; (2) GC Skew, purple-green; (3) B. paralicheniformis strain FA6 nucleotide sequence, red; (4) B. paralicheniformis_strainCBMAI1303 nucleotide sequence, blue; (5) B. paralicheniformis_SZA16 nucleotide sequence, green. The circular ring map was constructed by the BLAST Ring Image Generator (BRIG, version 0.95)
AntiSMASH identified secondary metabolite biosynthetic gene clusters (BGCs), including non-ribosomal peptide synthetases (NRPs), polyketide synthases (PKSs), ribosomally synthesized and post-translationally modified peptides (RiPPs), and other antimicrobial synthases. A total of 14 putative BGCs were identified in the genome of isolate SZA14, including 6 NRPs for lichenysin, fengycin, bacillibactin, bacitracin, one type III PKS, and one Ripp cluster for lanthipeptide, thiopeptide, and others (Table 2). Fourteen putative BGCs were reported from the isolates SZA16 and SZB3, which are presented in Supplementary Table S3.
Table 2.
List of identified secondary metabolite cluster of SZA14 using strictness “strict”
| Region | Type | From | To | Most similar known cluster | Similarity | |
|---|---|---|---|---|---|---|
| Region 1.1 | NRP-metallophore, NRPS | 179,782 bp | 226,948 bp | Bacillibactin/bacillibactin E/bacillibactin F | NRP | 100% |
| Region 1.2 | Lasso peptide | 329,843 bp | 352,304 bp | |||
| Region 2.1 | RiPP-like | 590, 754 bp | 601,098 bp | |||
| Region 3.1 | Thiopeptide, RiPP-like | 1 bp | 37,353 bp | Butirosin A/butirosin B | Saccharide | 7% |
| Region 3.2 | NRPS-independent-siderophore | 157, 466 bp | 172, 929 bp | Schizokinen | ||
| Region 6.1 | NRPS | 188, 517 bp | 253, 960 bp | Lichenysin | NRP | 100% |
| Region 7.1 | NRPS, betalactone | 143, 176 bp | 181, 683 bp | Fengycin | NRP | 60% |
| Region 8.1 | NRPS | 1 bp | 21,785 bp | Fengycin | NRP | 20% |
| Region 8.2 | Terpene | 11,337 bp | 139,226 bp | |||
| Region 9.1 | NRPS | 40,554 bp | 123,443 bp | Bacitracin | NRP | 100% |
| Region 11.1 | T3PKS | 63,325 bp | 104,422 | |||
| Region 14.1 | Lanthipeptide-class-ii, cyclic-lactone-autoinducer | 1 bp | 25,154 bp | Amyloliquecidin GF610 | Ripp | 93% |
| Region 23.1 | CDPS | 23,382 bp | 44,131 | Pulcherriminic acid | 66% | |
| Region 30.1 | NRPS | 1 bp | 13,447 bp | Fengycin | NRP | 20% |
When the SZA14 NRP gene cluster (region 6.1; lichenysin) translated sequence was compared to relevant proteins using BLASTp, they showed a significant degree of similarity to proteins involved in the synthesis of variant forms of lichenysin: LicA (100% B. paralicheniformis), LiB (100% B. paralicheniformis), and LiC (100% B. licheniformis). Another NRP cluster (region 30.1; fengycin) displayed 100% identity to non-ribosomal peptide synthetase produced by B. paralicheniformis. The translated sequence of region 9.1 NRPs gene cluster was found to be similar to the protein involved in variant forms of bacitracin produced by B. paralicheniformis: BacA (99.66%, WP_020452079.1), BacB (100%, AGN36974.1), and BacC (99.98%, WP_154059223.1). The translated sequence of the NRP cluster (bacillibactin; region 1.1) was 99.6% similar to that of non-ribosomal peptide synthetase from B. subtilis (WP_025810654). One hybrid gene cluster contained an NRP gene similar to fengycin. The BLASTp-translated sequence showed 99.92% similarity with the non-ribosomal peptide synthetase of B. subtilis (WP_059231152.1). Another NRP gene cluster was 99.83% similar to FenA synthetase produced by B. paralicheniformis. A Ripp-like gene cluster was found to be 99.12% similar to the uberolysin/carnocyclin family of circular bacteriocin produced by B. licheniformis (WP_051303766.1).
The antiSMASH reported gene clusters from the SZA16 genome were similar to the ones detected in the genome of SZA14, implicating their close relatedness. However, when the translated sequence of SZA16 region 2.1 NRP gene cluster was compared to relevant proteins using BLASTp, it showed significant similarity to proteins involved in the synthesis of variant forms of bacitracin produced by B. paralicheniformis: BacA (100%, WP_020452079.1), BacB (100%, WP_041817244.1), and BacC (100%, WP_020452077.1). The translated result of another region 4.1 exhibited a high degree of similarity to proteins involved in the synthesis of variant forms of lichenysin: LicA (100%, B. paralicheniformis, WP_020450105.1), LiB (100%, B. paralicheniformis, WP_020450106.1), and LiC (100%, B. licheniformis, AAD04759.1). NRP cluster (region 1.2; bacillibactin) was 100% similar to the non-ribosomal peptide synthetase produced by B. subtilis (WP_020453230.1). One hybrid gene cluster (region 3.1; NRPS-betalactone) displayed 100% identity to non-ribosomal peptide synthetase produced by B. paralicheniformis (WP_116758584.1). In another cluster (region 14.1, fengycin), the NRP gene cluster displayed 100% identity to non-ribosomal peptide synthetase produced by B. paralicheniformis (WP_145697799.1). A Ripp-like gene cluster (region 2.2) was found to be 99.12% similar to the uberolysin/carnocyclin, a family of circular bacteriocins produced by Bacillus sp. SB47 (WP_051303766.1).
When the translated sequences of the SZB3 NRP gene clusters (regions 5.1, 6.1, and 11.1) were compared to relevant proteins using BLASTp, they were found to be identical to surfactin non-ribosomal peptide synthetase SrfAC (99.92%, B. subtilis; WP_263723575.1), surfactin non-ribosomal peptide synthetase SrfAA (100%, B. subtilis; WP_116972609.1), and surfactin non-ribosomal peptide synthetase SrfAB (100%, B. subtilis; WP_010886403.1), respectively. A hybrid cluster (region 1.3) showed high similarity to variant forms of plipastatin produced by B. subtilis: PpsA (99.92%, WP_009967358.1), PpsB (100%, WP_003247155.1), PpsC (100%, WP_009967356.1), PpsD (100%, WP_009967354.1), and PpsE (99.92%, WP_009967353.1). Another gene cluster (region 2.3; sactipeptide) exhibited 100% identity to subtilosin A, a family of bacteriocins produced by B. subtilis. Blastp results for all strains are shown in (Supplementary Table S4).
BAGEL4 predicted open reading frames (ORFs) coding for ribosomally synthesized proteins and peptides, including bacteriocins and ribosomally synthesized and post-translationally modified peptides (RiPPs). Nine putative gene clusters of interest were reported in the genome of isolate SZA14 that involved genes related to the production of secondary metabolites, including sonorensin, UviB, lasso peptide, bottromycin, enterocin Nkr-5-3B, haloduracin_alpha, comX2, and two sactipeptides. However, due to high relatedness between SZA14 and SZA16 genomes, the six identified gene clusters: enterocin Nkr-5-3B, haloduracin-alpha, sonorensin, bottromycin, comX2, and lasso peptide were similar to the ones observed in the SZA14 genome. Four gene clusters were identified in the genome of isolate_SZB3. Genes for competence, sporulation-killing factor (skfA), subtilosin A (SboA), and sactipeptides were observed (Table 3).
Table 3.
List of identified RiPPs using BAGEL4 server
| Area of interest | Start | End | Class |
|---|---|---|---|
| Predicted RiPPs in SZA14 genome | |||
| lcl_Contig0014.11.AOI_01 | 1 | 24121 | 42.1;haloduracin_alpha |
| lcl_Contig002.16.AOI_01 | 585866 | 606094 | 272.1;enterocin_Nkr-5-3B |
| lcl_Contig003.1.AOI_01 | 34 | 20382 | 218.1;sonorensin |
| lcl_Contig003.1.AOI_02 | 16367 | 36367 | Bottromycin |
| lcl_Contig001.20.AOI_01 | 332234 | 352234 | Lasso peptide |
| lcl_Contig001.20.AOI_02 | 211718 | 231718 | Sactipeptide |
| lcl_Contig0015.2.AOI_01 | 1313 | 21313 | Sactipeptide |
| lcl_Contig005.4.AOI_01 | 76192 | 96312 | 319.1;comX2 |
| lcl_Contig0031.7.AOI_01 | 0 | 10472 | 225.2;UviB |
| Predicted RiPPs in SZA16 genome | |||
| lcl_Contig002.14.AOI_01 | 212678 | 232870 | 272.1;enterocin_Nkr-5-3B |
| lcl_Contig009.1.AOI_01 | 1 | 24412 | 42.1;haloduracin_alpha |
| lcl_Contig008.6.AOI_01 | 112938 | 133265 | 218.1;sonorensin |
| lcl_Contig008.6.AOI_02 | 129290 | 149290 | Bottromycin |
| lcl_Contig001.7.AOI_01 | 975059 | 995179 | 319.1;comX2 |
| lcl_Contig001.7.AOI_02 | 334985 | 354985 | Lasso peptide |
| Predicted RiPPs in SZB3 genome | |||
| lcl_Contig006.0.AOI_01 | 160205 | 180776 | 121.1;sporulation-killingfactor_skfA |
| lcl_Contig002.11.AOI_01 | 378503 | 399115 | 216.2;subtilosin_(SboX) |
| lcl_Contig003.2.AOI_01 | 67128 | 87290 | 492.1;competence |
| lcl_Contig004.4.AOI_01 | 67577 | 87577 | Sactipeptides |
Prophage identification and analysis
Full-length genome assemblies for each sample allowed the prediction of the closest putative prophage. A total of 11 prophages were detected in the SZA14 genome using the Phage Hunter server, which included three active and eight ambiguous prophages (Supplementary Table 5a). SZA16 yielded ten prophage candidates, four of which were active and six were ambiguous (Supplementary Table S5b). Whereas, out of the 12 predicted prophage candidates identified in the SZB3 genome, eight were active and four were ambiguous (Supplementary Table S5c).
Homology modeling
The peptide sequences predicted by the antiSMASH and BAGEL4 servers in the genomes of all three strains were searched for closely related structures on the Phyre2 server. One peptide sequence from SZA14 and SZA16 (referred to as peptide1 hereafter) was found to be closely related to enterocin NKR-5-3B. Whereas, another peptide sequence (referred to as peptide 2) from both SZA14 and SZA16 was closely related to lichenicidin vk21-a1. For SZB3, one peptide sequence was found to be similar to subtilosin A (Table 4).
Table 4.
Phyre2 query results of peptides
| Query peptide | Closely related template | PDB ID | Confidence | Coverage | Identity |
|---|---|---|---|---|---|
| SZA14 peptide1 | Enterocin NKR-5-3B | 2MP8 | 100.0% | 98.0% | 58.0% |
| SZA14 peptide2 | Lichenicidin vk21 a1 | 2KTN | 88.2% | 49.0% | 59.0% |
| SZA16 peptide1 | Enterocin NKR-5-3B | 2MP8 | 100.0% | 56.0% | 58.0% |
| SZA16 peptide2 | Lichenicidin vk21 a1 | 2KTN | 88.2% | 49.0% | 59.0% |
| SZB3 peptide1 | Subtilosin A | 1PXQ | 99.7% | 94.0% | 97.0% |
Homology models of peptides were generated using the Swiss modeling server. Enterocin NKR-5-3B was selected as a template for SZA14_peptide1 (Fig. 5a) and SZA16_peptide1 (Fig. 5c), while lichenicidin vk21-a1 was selected as a template for SZA14_peptide2 (Fig. 5b) and SZA16_peptide2 (Fig. 5d). Subtilosin A was selected as a template for SZB3_peptide1 (Fig. 5e). Peptide structures were superimposed with Chimera, revealing structural deviations at specific positions due to sequence variation as observed by multiple sequence alignment (Supplementary Figure S2). Both SZA14 peptide 1 and SZA16 peptide 1 had a threonine inserted at position 39 in the coil region. Similarly, SZA14_peptide2 and SZA16_peptide2 exhibited deviation at several positions. A seven-residue portion was missing and no modified amino acids were observed. At position 8, a tyrosine was found instead of an alanine. At position 9, asparagine was present in place of isoleucine, and at position 10, the reference leucine was replaced by isoleucine. At position 23, a valine was found in the reference, while peptide 2 had a threonine at that place. At position 26 in peptide 2, leucine insertion was observed. In the SZB3 peptide structure, the first two residues, asparagine and lysine, and modified D-amino acids were missing at positions 28 and 31 compared to the reference subtilosin A sequence.
Fig. 5.
Homology models of the predicted peptide sequences. a Superposed structure of SZA14_peptide1 (blue) with enterocin NKR-5-3B PDB ID 2MP8 (red); b superposed structure of SZA14_peptide2 (blue) with lichenicidin vk21 a1 PDB ID 2KTN (red); c superposed structure of SZA16_peptide1 (blue) with enterocin NKR-5-3B PDB ID 2MP8 (red); d superposed structure of SZA16_peptide2 (blue) with lichenicidin vk21 a1 PDB ID 2KTN (red); e superposed structure of SZB3_peptide (blue) with subtilosinA PDB ID 1PXQ (red). The highlighted yellow area shows the structural deviation
Identification of enzymes with biotechnological potential
Prokaryotic genome annotation pipeline (PGAP) analysis resulted in 4416, 4270, and 4348 annotated protein sequences for SZA14, SZA16, and SZB3, respectively. The meta server, dbCAN2, classified enzymes and enzymes annotated via all three tools. HMMER: dbCAN, DIAMOND: CAZy, and HMMER: dbCAN-sub were considered significant. From the 4416 genes in the isolate SZA14 genome, 146 were identified by dbCAN as belonging to carbohydrate-active enzyme families. These 146 genes included 40 conserved Carbohydrate-Active enZYme (CAZy) domains whose genes had signal peptides. These CAZy domains represented CAZy families, including two auxiliary activity families (AA), four carbohydrate binding module families (CBM), seven carbohydrate esterase families (CE), 38 glycoside hydrolase families (GH), ten glycosyl transferase families (GT), and seven polysaccharide lyase families (PL). The SZA16 genome encoded 150 CAZy families, with 40 having conserved signal peptides. These CAZy domains include three auxiliary activity families (AA), four carbohydrate binding module families (CBM), seven carbohydrate esterase families (CE), 43 glycoside hydrolase families (GH), ten glycosyl transferase families (GT), and seven polysaccharide lyase families (PL). Alternatively, the SZB3 genome consists of 138 CAZy domains, and 34 of those 138 CAZy domains have conserved signal peptides. Three entries for auxiliary activity families (AA), six carbohydrate binding module families (CBM), seven carbohydrate esterase families (CE), twenty-nine glycoside hydrolase families (GH), ten glycosyl transferase families (GT), and six polysaccharide lyase families (PL). The signal peptide-containing glycoside hydrolase family was the largest group of carbohydrate-active enzymes. A Venn diagram of the annotated enzymes is presented in Fig. 6. EC terms were assigned and the entries were searched manually in the AMFEP list and BRENDA database for their biotechnological potential and industrial applications (Supplementary Table S6).
Fig. 6.
A series of comparative Venn diagrams of the secreted carbohydrate-active enzymes from SZA14 (orange), SZA16 (grey), and the SZB3 strain (blue)
Peptides with expected antimicrobial activity
Finally, small peptides in the genomes of SZA14, SZA16, and SZB3 not covered in the previous analyses were identified. The commonly predicted peptides ≤ 100 amino acids by the AMPA (Torrent et al. 2012), ADAM (Lee et al. 2015), and CAMPR4 (Waghu et al. 2016) databases were searched against the APD3 database, as shown in Table 5. From the SZA14 genome, eight peptides were predicted. Peptide 2, a 13-residue peptide, exhibited the highest sequence similarity of 53.33% to peptide paenibacterin, followed by peptide 1, a 14-residue peptide showing 42.86% similarity to PE1 and a 13-residue peptide exhibiting 42.86% similarity to polymyxin B. Similarly, from the SZA16 genome, 12 peptides were predicted. Peptide 3, a 13-residue peptide, was found to be similar to paenibacterin with 53.33% similarity while peptide 11, a 12-residue peptide, was 46.15% similar to PE1. Nine peptides were predicted from the SZB3. Peptide 4 was found to be 50% similar to SyCPA-12 and peptide 2 was 43.75% to paenibacterin.
Table 5.
BLAST results of predicted peptides against APD3 database
| S. no | Sequence | APD3 database similarity/APD ID | Peptide name | Organism |
|---|---|---|---|---|
| SZA14 predicted peptides | ||||
| 1 | K V F I L F Y L W I V P L V | 42.86%/AP02201 | PE1 | Paenibacillus ehimensis B7 |
| 2 | K K V F K S A V K W A P V | 53.33%/AP02347 | Paenibacterin | Paenibacillus thiaminolyticus OSY |
| 3 | S K H Q R I K I I K I L E | 40%/AP03331 | Brevibacillin i | Brevibacillus laterosporus DSM 25 |
| 4 | V K R L T W I I P I V L | 40%/AP02243 | Gramicidin s | Bacillus brevis |
| 5 | Y Y R F C H Q N V G R V A R I T | 42.11%/AP02376 | Lassomycin | Lentzea kentuckyensis sp |
| 6 | T V A K K R F G L M R I T | 42.86%/AP02928 | Polymyxin b | Bacillus aerosporus Greer |
| 7 | L I I K S K W K K V K T | 42.86%/AP02204 | Colistin a | Paenibacillus polymyxa var. colistinus |
| 8 | L L I A W R R K R R Q A G | 41.18%/AP02678 | Plantaricin Y | Lactiplantibacillus plantarum |
| SZA16 predicted peptides | ||||
| 1 | V R L I N K K G T V L I Y R | 40%/AP03519 | P3 | Brevibacillus sp. SPR-20 |
| 2 | L L L I A W R R K R R K A G | 41.18%/AP02678 | Plantaricin Y | L. plantarum |
| 3 | K K V F K S A V K W A P V | 53.33%/AP02347 | Paenibacterin | Paenibacillus thiaminolyticus OSY-SE |
| 4 | E G K K S K K K N R A F | 40%/AP02779 | Tridecaptin B1 | Paenibacillus polymyxa NRRL B-30507 |
| 5 | N I K L Q R I T L T G H | 38.46%/AP02201 | PE1 | P. ehimensis B7 |
| 6 | V Y N R L L K Y N W F L R K L Y F A L Y | 40.91%/AP03562 | P4 | Brevibacillus sp. SPR-20 |
| 7 | V K R L T W I I P I V L | 40%/AP02243 | Gramicidin S | Bacillus brevis |
| 8 | T K K V S G Y I T W Y N G V G K V G | 40.91%/AP03460 | Triculamin | Streptomyces triculaminicus JCM 4242 |
| 9 | H W H I G Y K F T I F N | 38.46%/AP03267 | Brevicidine | B. laterosporus DSM 25 |
| 10 | Y E R Y L R L N R R R H K E G G | 35.29%/AP02678 | Plantaricin Y | L. plantarum |
| 11 | K R I L K Q K A L F C T | 46.15%/AP02201 | PE1 | P. ehimensis B7 |
| 12 | T V K L V G I Q K R F L P I C | 40%/AP02243 | Gramicidin S | B. brevis |
| SZB3 predicted peptides | ||||
| 1 | K R V I R Q K A L V C S T | 42.86%/AP02201 | PE1 | P. ehimensis B7 |
| 2 | K T V Y T K Q K M L Q V N K | 43.75%/AP02347 | Paenibacterin | P. thiaminolyticus OSY-SE |
| 3 | G I I I Y F I V K Y V M N R N | 41.18%/AP03331 | brevibacillin I | B. laterosporus DSM 25 |
| 4 | K R L K H A F K P K V T | 50%/AP03316 | SyCPA 12 | Dickeya dadantii Ech586 |
| 5 | T I I H G F K V R P L Y L I | 43.75%/AP03326 | Bogorol K | Brevibacillus laterosporus MG64 |
| 6 | P K C N A L F L K T K L Q T V | 40%/AP02928 | Polymyxin B | B. aerosporus Greer |
| 7 | S Y I V Q T L I V C I A I Y A | 42.11%/AP01605 | Actagardine | Actinoplanes garbadinensis ATCC31048 and 31049 |
| 8 | V S R L V H L Y G G V I | 42.86%/AP02688 | Griselimycin | Streptomyces |
| 9 | R W S K W F N V F C I V A L | 41.18%/AP02777 | Tridecaptin A1 | Paenibacillus terrae |
Discussion
For centuries, honey has been used as “folk medicine” (Molan 2015). Honey exhibits an antimicrobial effect against several bacterial (Cooper et al. 2002b, a; Gambo et al. 2018; Grecka et al. 2018) and fungal species (Irish et al. 2006; de Groot et al. 2021). Different factors like the osmotic effect, acidity, hydrogen peroxide, bee defensins, and phytochemicals are attributed to the antimicrobial activity of honey (Brudzynski 2020; Almasaudi 2021; Majtan et al. 2021). Nevertheless, it is also postulated that the additional antimicrobial activity is due to proteinaceous compounds secreted by the gut microbiota of honey bees prior to honey maturation (Mundo et al. 2004; Lee et al. 2008b; Brudzynski 2021). It is now known that raw honey is a reservoir for several microbial species like mold, yeast, and spore-forming bacteria (Snowdon and Cliver 1996).
Recent studies have shown that most of the bacterial isolates recovered from honey can exhibit antimicrobial activity and are a promising source of novel antimicrobials (Lee et al. 2008b, a; Pajor et al. 2018, 2020; Wadi 2022; Xiong et al. 2022). In this study, we isolated three Bacillus strains from the honey samples collected from different locations of the same apiary. The isolates exhibited antibacterial activity against the reference S. aureus strain both in the overlay inhibition and cell-free supernatant/cell-free after-culture medium (CFAM) assays, following the results obtained by (Pajor et al. 2018).
A large portion of Bacillus genome undergoes secondary metabolism and synthesizes diverse secondary metabolites exhibiting broad-spectrum antimicrobial activity (Motta et al. 2008; Li et al. 2012; Sabaté and Audisio 2013). Based on their origin and synthesis pathway, they are classified into two sub-groups: (i) ribosomally synthesized peptides, named bacteriocins, and (ii) non-ribosomally synthesized peptides (NRPs), formed from large enzymatic complexes (Bin Hafeez et al. 2021).
We detected secondary metabolite gene clusters along with lipopeptide antibiotics or proteins in our isolates. The predicted clusters include bacillibactin, butirosin A/B, lichenysin, fengycin, bacitracin, pulcherriminic acid, and amyloliquecidin GF610 from SZA14 and SZA16 and fengycin, bacillaene, thailanstatin A, bacilysin, subtilosin A, bacillibactin, surfactin, pulcherriminic acid, and sporulation-killing factor, from the isolate SZB3.
Bacillibactin (DHB–Gly–Thr) is a cyclic catecholic siderophore (May et al. 2001). Dimopoulou et al. (2021), in a recent study, isolated and characterized the catecholate siderophore bacillibactin from B. amyloliquefaciens MBI600 and demonstrated its association with susceptibility in non-susceptible bacterial and fungal phytopathogens. Similarly, Chakraborty et al. (2022) isolated siderophore-type bacillibactin from Bacillus amyloliquefaciens MTCC 12,713 and described its bactericidal activity against multidrug-resistant pathogens S. aureus, Klebsiella pneumoniae, vancomycin-resistant Enterococcus faecalis, and Pseudomonas aeruginosa causing nosocomial infections (Chakraborty et al. 2022).
Butirosin is an aminoglycosidic antibiotic complex (Dion et al. 1972). It exhibits potent in vitro and in vivo activity against several gram-positive and gram-negative bacteria, including P. aeruginosa (Heifetz et al. 1972). However, we observed low sequence identity of butirosin A/B clusters in B. paralicheniformis_SZA14 and B. paralicheniformis_SZA16 genomes indicating sequence variation and novelty of these honey isolates.
Lichenysin is an anionic lipopeptide produced by Bacillus spp (Coronel et al. 2016, 2017). They possess cytotoxic, antimicrobial, and hemolytic activities and have a wide range of potential uses in chemical and biological fields (Ruiz et al. 2017; Coronel et al. 2017). The gene clusters with 100% sequence identity were observed in the genome of B. paralicheniformis_SZA14 and B. paralicheniformis_SZA16.
Fengycins are cyclic lipo-depsipeptides (CLiPs) synthesized by Bacillus spp. and display strong antifungal properties. To date, several variants of fengycin have been described: fengycin A and B, A2, B2, and C2 (Ongena and Jacques 2008), fengycin C (Vater et al. 2002), fengycin D and S (Yang et al. 2015), and fengycin X and Y (Ait Kaki et al. 2020). Apart from antifungal activity, it also exhibits antitumor activity and inhibits human colon cancer HT29 cell line and human lung cancer cell line 95D (Yin et al. 2013; Cheng et al. 2016). The gene clusters observed in the B. paralicheniformis_SZA14 and B. paralicheniformis_SZA16 genomes displayed a low sequence identity of 20% implicating more in-depth analysis of these regions to look for some novel NRPs.
Bacitracin possesses strong broad-spectrum antibiotic activity against gram-positive bacteria (Weinberg 1967). Luo et al. (2023) reported the production of bacitracin from B. paralicheniformis CPL618 and its anti-staphylococcal activity. Bacitracin interferes with cell wall synthesis by inhibiting the dephosphorylation of the lipid carrier (Ming and Epperson 2002). Moreover, it was shown that bacitracin might also cause the degradation of double-stranded DNA (Tay et al. 2010).
Amyloliquecidin is a relatively new two-component (α and β peptides) lantibiotic (Gerst et al. 2022). It is active against most of the tested gram-positive species, which include Listeria monocytogenes, Clostridium sporogenes, Clostridioides difficile, S. aureus (Van Staden et al. 2016), and Alicyclobacillus acidoterrestri (Gerst et al. 2022). Amyloliquecidin gene clusters within the SZA14 and SZA16 genomes are present in contigs 14 and 9, respectively. While Gerst et al. (2022) in their study reported the presence of amyloliquecidin in contig 19. So far, the gene cluster for lantibiotic amyloliquecidin has been reported in four strains from different locations: Bacillus spp. 275, isolated in Korea (Gong et al. 2017), B. amyloliquefaciens UMAF6639, reported in Spain (Magno-Perez-Bryan et al. 2015), B. subtilis subsp. subtilis strain SRCM100333 (Accession: CP021892.1, South Korea), and B. velezensis GF610, reported in the USA (Gerst et al. 2022).
Bacillaene is a polyene antibiotic isolated from B. subtilis fermentation broths (Mayerl et al. 1995). The compound is produced by the enzymatic megacomplex non-ribosomal peptide synthetases (NRPS) and polyketide synthases (PKS), encoded on a biosynthetic PKS gene cluster (Straight et al. 2007). In agar-plate diffusion experiments, the antibiotic bacillaene is found effective against a wide variety of microorganisms (Mayerl et al. 1995). In vitro studies indicate that bacillaene selectively inhibits prokaryotic protein synthesis (Mayerl et al. 1995). Cell survival studies conducted on Escherichia coli indicate its function as a bacteriostatic agent (Mayerl et al. 1995). Bacillaene is thought to play a significant role in B. subtilis–based probiotics (Erega et al. 2021; Torres-Sánchez et al. 2021) and functions as an antagonist in a variety of interspecies interactions and prevents B. subtilis from predation by Myxococcus xanthus (Straight et al. 2007; Yang et al. 2009; Barger et al. 2012).
B. subtilis_SZB3 displayed high identity with bacilysin gene cluster, a dipeptide compound produced by spore-forming Bacillus causing bacterial and fungal cell lysis (Kenig and Abraham 1976). Nannan et al. (2021) found bacilysin to be a major player in the antagonistic activity of B. velezensis against gram-negative foodborne pathogens. The proposed mechanism of action of bacilysin is that it interferes with bacterial cell wall synthesis by inhibiting glucosamine 6-phosphate (GlcN6P) synthase or fungal mannoprotein synthesis (Kenig et al. 1976; Khan et al. 2016). Subtilosin A is a 35-residue macrocyclic peptide encoded by the sbo-albABCDEFG gene cluster (Ishida et al. 2022). The mature peptide is generated from its precursor by proteolytic cleavage of the N-terminal leader peptide and cyclization through covalent bonds between the N-terminal asparagine and the C-terminal glycine (Kawulka et al. 2003). Subtilosin A demonstrates bactericidal activity against Listeria monocytogenes, clinical isolates of Gardnerella vaginalis and Streptococcus agalactiae, and some gram-negative bacteria (Shelburne et al. 2007; Sutyak et al. 2008).
Sporulation-killing factor (SKF) is a ribosomally synthesized and post-translationally modified peptide (Ripp) (González-Pastor et al. 2003). B. subtilis exhibits cannibalism under nutrient-stress conditions (González-Pastor et al. 2003). Nandy et al. (2007) in their study reported the Spo0A-mediated killing of E. coli, P. aeruginosa, Acinetobactor lwoffi, and Xanthomonas campestris by B. subtilis in mixed cultures. Pulcherriminic acid interacts with extracellular ferric ions to form a red pigment pulcherrimin (Kántor et al. 2015). Kántor et al. (2015) reported in their study that pulcherrimin efficiently inhibits the growth of yeast and fungus and also affects the formation of biofilms.
COG analysis revealed S-function unknown to be the dominant COG category, which, however, indicates the potential of these isolates that still needs to be identified. Secondly, the CAZyme analysis provided insight into the enzymatic landscape of the bacteria present in honey. Thiruvengadam et al. (2022) isolated B. subtilis Bbv57 from the betel vine rhizosphere and found glycosyl transferases and glycoside hydrolases present predominantly in the genome. Endo β 1, 4 glucanase, chitinase, endoglucanase, and xyloglucanase were also detected in their study (Thiruvengadam et al. 2022). In another study, Chen et al. (2022) isolated B. subtilis CTXW 7–6-2 from kiwi fruit and observed the same results. These enzymes, such as glycosyl transferases, glycoside hydrolases, and carbohydrate esterase-related enzymes, are considered to be involved in the synthesis of secondary metabolites via non-ribosomal pathways, while others like chitinase, chitosanase, endoglucanase, and lysozyme can possibly be involved in the synthesis of antifungal CAZymes (Kumar et al. 2019; Chen et al. 2022). A similar CAZymes landscape observed in our isolates draws attention towards the secretion of these enzymes/products into the medium (honey), enhancing their therapeutic potential.
The hypothetical proteins and peptides were analyzed using AMPA, ADAM, and CAMPR4 algorithms to predict their antimicrobial potential (Pavlova et al. 2020). However, given the low accuracy and prediction power of peptide tools, experimental determination of peptides and their activities is necessarily required for further research into these potential AMPs. Structural variations observed by multiple sequence alignments and homology modeling enabled us to observe the missing residues observed in the structure of the peptides as a result of the directly translated gene product, which would otherwise have undergone extensive post-translational modifications by bacterial machinery inside a cell. However, multiple sequence alignments still depict the expected changes in the peptides.
Phage-mediated recombination is an essential event for environmental bacteria to exchange genetic information, which confers a variety of favorable traits like evolution and adaptability as well as the acquisition of antibiotic resistance or producing genes (Iqbal et al. 2023). We reported the presence of prophages in the genomes of all three isolates: SZA14, SZA16, and SZB3. We hypothesize that active prophages might be responsible for some important enzyme synthesis and stress-related proteins and even antimicrobial peptides. However, no detailed analysis was performed regarding phage hunting.
In this study, we reported three bacterial isolates able to produce potent antimicrobial peptides and enzymes with biotechnological potential. In addition, we also found the predominant presence of Bacillus sp. in the majority of the samples. However, extensive wet lab experiments assisted by computational studies are needed to further exploit the potential of these isolates.
Supplementary Information
Below is the link to the electronic supplementary material.
Author contribution
Conceptualization, P. S., R. W. W., and A. B. H.; methodology, A. B. H., K. P., and K. B.; formal analysis, A. B. H., P. S., R. W. W.; investigation, A. B. H., K. P., and K. B.; curation, A. B. H.; writing—original draft preparation, A. B. H., P. S.; writing—review and editing, A. B. H., P. S., R. W. W.; supervision, P. S.; project administration, P. S.; funding acquisition.
Funding
The studies were financed by the grant UMO-2021/41/B/NZ9/03929 from the National Science Centre, Poland.
Data availability
The data presented in this study are available on request from the corresponding author.
Declarations
Ethics approval
This article does not contain any studies with human participants or animals performed by any of the authors.
Competing interests
The authors declare no competing interests.
Footnotes
Publisher's note
Springer Nature remains neutral with regard to jurisdictional claims in published maps and institutional affiliations.
Contributor Information
Ahmer Bin Hafeez, Email: ahmer.bin.hafeez@pg.edu.pl.
Karolina Pełka, Email: karolina.pelka@pg.edu.pl.
Kamila Buzun, Email: buzunkamila@gmail.com.
Randy Worobo, Email: rww8@cornell.edu.
Piotr Szweda, Email: piotr.szweda@pg.edu.pl.
References
- Ait Kaki A, Smargiasso N, Ongena M, Kara Ali M, Moula N, De Pauw E, KacemChaouche N. Characterization of new fengycin cyclic lipopeptide variants produced by Bacillus amyloliquefaciens (ET) originating from a Salt Lake of Eastern Algeria. Curr Microbiol. 2020;77:443–451. doi: 10.1007/s00284-019-01855-w. [DOI] [PubMed] [Google Scholar]
- Al-Jabri AA. Honey, milk and antibiotics. African J Biotechnol. 2013;4:1580–1587. doi: 10.4314/u.v4i13.c. [DOI] [Google Scholar]
- Almasaudi S. The antibacterial activities of honey. Saudi J Biol Sci. 2021;28:2188–2196. doi: 10.1016/J.SJBS.2020.10.017. [DOI] [PMC free article] [PubMed] [Google Scholar]
- Barger SR, Hoefler BC, Cubillos-Ruiz A, Russell WK, Russell DH, Straight PD. Imaging secondary metabolism of Streptomyces sp. Mg1 during cellular lysis and colony degradation of competing Bacillus subtilis. Antonie Van Leeuwenhoek, Int J Gen Mol Microbiol. 2012;102:435–445. doi: 10.1007/s10482-012-9769-0. [DOI] [PubMed] [Google Scholar]
- Bin Hafeez A, Jiang X, Bergen PJ, Zhu Y (2021) Antimicrobial peptides: an update on classifications and databases. Int J Mol Sci 22 10.3390/IJMS222111691 [DOI] [PMC free article] [PubMed]
- Blin K, Shaw S, Kloosterman AM, Charlop-Powers Z, Van Wezel GP, Medema MH, Weber T. antiSMASH 6.0: improving cluster detection and comparison capabilities. Nucleic Acids Res. 2021;49:W29–W35. doi: 10.1093/NAR/GKAB335. [DOI] [PMC free article] [PubMed] [Google Scholar]
- Bolger AM, Lohse M, Usadel B. Trimmomatic: a flexible trimmer for Illumina sequence data. Bioinformatics. 2014;30:2114–2120. doi: 10.1093/BIOINFORMATICS/BTU170. [DOI] [PMC free article] [PubMed] [Google Scholar]
- Brudzynski K (2020) A current perspective on hydrogen peroxide production in honey. A review. Food Chem 332 10.1016/J.FOODCHEM.2020.127229 [DOI] [PubMed]
- Brudzynski K. Honey as an ecological reservoir of antibacterial compounds produced by antagonistic microbial interactions in plant nectars, honey and honey bee. Antibiot 2021. 2021;10:551. doi: 10.3390/ANTIBIOTICS10050551. [DOI] [PMC free article] [PubMed] [Google Scholar]
- Cantalapiedra CP, Hernández-Plaza A, Letunic I, Bork P, Huerta-Cepas J. eggNOG-mapper v2: functional annotation, orthology assignments, and domain prediction at the metagenomic scale. Mol Biol Evol. 2021;38:5825–5829. doi: 10.1093/MOLBEV/MSAB293. [DOI] [PMC free article] [PubMed] [Google Scholar]
- Chakraborty K, Kizhakkekalam VK, Joy M, Chakraborty RD. Bacillibactin class of siderophore antibiotics from a marine symbiotic Bacillus as promising antibacterial agents. Appl Microbiol Biotechnol. 2022;106:329–340. doi: 10.1007/s00253-021-11632-0. [DOI] [PubMed] [Google Scholar]
- Chen T, Zhang Z, Li W, Chen J, Chen X, Wang B, Ma J, Dai Y, Ding H, Wang W, Long Y. Biocontrol potential of Bacillus subtilis CTXW 7–6-2 against kiwifruit soft rot pathogens revealed by whole-genome sequencing and biochemical characterisation. Front Microbiol. 2022;13:1069109. doi: 10.3389/FMICB.2022.1069109. [DOI] [PMC free article] [PubMed] [Google Scholar]
- Cheng W, Feng YQ, Ren J, Jing D, Wang C. Anti-tumor role of Bacillus subtilis fmbJ-derived fengycin on human colon cancer HT29 cell line. Neoplasma. 2016;63:215–222. doi: 10.4149/206_150518N270. [DOI] [PubMed] [Google Scholar]
- Cooper RA, Halas E, Molan PC. The efficacy of honey in inhibiting strains of Pseudomonas aeruginosa from infected burns. J Burn Care Rehabil. 2002;23:366–370. doi: 10.1097/00004630-200211000-00002. [DOI] [PubMed] [Google Scholar]
- Cooper RA, Molan PC, Harding KG. The sensitivity to honey of gram-positive cocci of clinical significance isolated from wounds. J Appl Microbiol. 2002;93:857–863. doi: 10.1046/J.1365-2672.2002.01761.X. [DOI] [PubMed] [Google Scholar]
- Coronel JR, Aranda FJ, Teruel JA, Marqués A, Manresa Á, Ortiz A. Kinetic and structural aspects of the permeabilization of biological and model membranes by lichenysin. Langmuir. 2016;32:78–87. doi: 10.1021/acs.langmuir.5b04294. [DOI] [PubMed] [Google Scholar]
- Coronel JR, Marqués A, Manresa Á, Aranda FJ, Teruel JA, Ortiz A. Interaction of the lipopeptide biosurfactant lichenysin with phosphatidylcholine model membranes. Langmuir. 2017;33:9997–10005. doi: 10.1021/acs.langmuir.7b01827. [DOI] [PubMed] [Google Scholar]
- Darling ACE, Mau B, Blattner FR, Perna NT. Mauve: multiple alignment of conserved genomic sequence with rearrangements. Genome Res. 2004;14:1394–1403. doi: 10.1101/GR.2289704. [DOI] [PMC free article] [PubMed] [Google Scholar]
- de Groot T, Janssen T, Faro D, Cremers NAJ, Chowdhary A, Meis JF. Antifungal activity of a medical-grade honey formulation against Candida auris. J Fungi 2021. 2021;7:50–7:50. doi: 10.3390/JOF7010050. [DOI] [PMC free article] [PubMed] [Google Scholar]
- Didaras NA, Karatasou K, Dimitriou TG, Amoutzias GD, Mossialos D. Antimicrobial activity of bee-collected pollen and beebread: state of the art and future perspectives. Antibiot. 2020;9:811–9:811. doi: 10.3390/ANTIBIOTICS9110811. [DOI] [PMC free article] [PubMed] [Google Scholar]
- Dimopoulou A, Theologidis I, Benaki D, Koukounia M, Zervakou A, Tzima A, Diallinas G, Hatzinikolaou DG, Skandalis N (2021) Direct antibiotic activity of bacillibactin broadens the biocontrol range of Bacillus amyloliquefaciens MBI600. mSphere 6 10.1128/msphere.00376-21 [DOI] [PMC free article] [PubMed]
- Dion HW, Woo KPW, Willmer NE, Kern DL, Onaga J, Fusari SA, Woo WKBP, Coffey GL, Dion HW, Fusari SA, Senos GD, Pat U. Butirosin, a new aminoglycosidic antibiotic complex: isolation and characterization. Antimicrob Agents Chemother. 1972;2:84–88. doi: 10.1128/AAC.2.2.84. [DOI] [PMC free article] [PubMed] [Google Scholar]
- Erega A, Stefanie P, Dogsa I, Danevčič T, Simunovic K, Klančnik A, Možina SS, Mulec IM (2021) Bacillaene mediates the inhibitory effect of Bacillus subtilis on Campylobacter jejuni biofilms. Appl Environ Microbiol 87 10.1128/AEM.02955-20 [DOI] [PMC free article] [PubMed]
- Farris JS. Estimating phylogenetic trees from distance matrices. Am Nat. 1972;106:645–668. doi: 10.1086/282802. [DOI] [Google Scholar]
- Fernandes L, Oliveira A, Henriques M, Rodrigues ME. Honey as a strategy to fight Candida tropicalis in mixed-biofilms with Pseudomonas aeruginosa. Antibiot. 2020;9:43–9:43. doi: 10.3390/ANTIBIOTICS9020043. [DOI] [PMC free article] [PubMed] [Google Scholar]
- Gambo SB, Ali M, Diso SU, Abubakar NS. Antibacterial activity of honey against Staphylococcus aureus and Pseudomonas aeruginosa isolated from infected wound. Arch Phar Pharmacol Res. 2018;1:2018. [Google Scholar]
- Gardner SN, Hall BG. When whole-genome alignments just won’t work: kSNP v2 software for alignment-free SNP discovery and phylogenetics of hundreds of microbial genomes. PLoS One. 2013;8:e81760. doi: 10.1371/JOURNAL.PONE.0081760. [DOI] [PMC free article] [PubMed] [Google Scholar]
- Gerst MM, Somogyi Á, Yang X, Yousef AE. Detection and characterization of a rare two-component lantibiotic, amyloliquecidin GF610 produced by Bacillus velezensis, using a combination of culture, molecular and bioinformatic analyses. J Appl Microbiol. 2022;132:994–1007. doi: 10.1111/JAM.15290. [DOI] [PubMed] [Google Scholar]
- Gong G, Kim S, Lee SM, Woo HM, Park TH, Um Y. Complete genome sequence of Bacillus sp. 275, producing extracellular cellulolytic, xylanolytic and ligninolytic enzymes. J Biotechnol. 2017;254:59–62. doi: 10.1016/J.JBIOTEC.2017.05.021. [DOI] [PubMed] [Google Scholar]
- González-Pastor JE, Hobbs EC, Losick R. Cannibalism by sporulating bacteria. Science (80-) 2003;301:510–513. doi: 10.1126/science.1086462. [DOI] [PubMed] [Google Scholar]
- Goris J, Konstantinidis KT, Klappenbach JA, Coenye T, Vandamme P, Tiedje JM. DNA-DNA hybridization values and their relationship to whole-genome sequence similarities. Int J Syst Evol Microbiol. 2007;57:81–91. doi: 10.1099/IJS.0.64483-0. [DOI] [PubMed] [Google Scholar]
- Grabowski NT, Klein G. Microbiology and foodborne pathogens in honey. Crit Rev Food Sci Nutr. 2017;57:1852–1862. doi: 10.1080/10408398.2015.1029041. [DOI] [PubMed] [Google Scholar]
- Grecka K, Kús PM, Worobo RW, Szweda P (2018) Study of the anti-Staphylococcal potential of honeys produced in Northern Poland. Molecules 23 10.3390/MOLECULES23020260 [DOI] [PMC free article] [PubMed]
- Gurevich A, Saveliev V, Vyahhi N, Tesler G. QUAST: quality assessment tool for genome assemblies. Bioinformatics. 2013;29:1072–1075. doi: 10.1093/BIOINFORMATICS/BTT086. [DOI] [PMC free article] [PubMed] [Google Scholar]
- Harwood CR, Mouillon JM, Pohl S, Arnau J. Secondary metabolite production and the safety of industrially important members of the Bacillus subtilis group. FEMS Microbiol Rev. 2018;42:721–738. doi: 10.1093/FEMSRE/FUY028. [DOI] [PMC free article] [PubMed] [Google Scholar]
- Heifetz CL, Fisher MW, Chodubski JA, DeCarlo MO. Butirosin, a new aminoglycosidic antibiotic complex: antibacterial activity in vitro and in mice. Antimicrob Agents Chemother. 1972;2:89–94. doi: 10.1128/AAC.2.2.89. [DOI] [PMC free article] [PubMed] [Google Scholar]
- Iqbal S, Qasim M, Rahman H, Khan N, Paracha RZ, Bhatti MF, Javed A, Janjua HA. Genome mining, antimicrobial and plant growth-promoting potentials of halotolerant Bacillus paralicheniformis ES-1 isolated from salt mine. Mol Genet Genomics. 2023;298:79–93. doi: 10.1007/s00438-022-01964-5. [DOI] [PubMed] [Google Scholar]
- Irish J, Carter DA, Shokohi T, Blair SE. Honey has an antifungal effect against Candida species. Med Mycol. 2006;44:289–291. doi: 10.1080/13693780500417037. [DOI] [PubMed] [Google Scholar]
- Ishida K, Nakamura A, Kojima S. Crystal structure of the AlbEF complex involved in subtilosin A biosynthesis. Structure. 2022;30:1637–1646.e3. doi: 10.1016/J.STR.2022.10.002. [DOI] [PubMed] [Google Scholar]
- Kántor A, Hutková J, Petrová J, Hleba L, Kačániová M. Antimicrobial activity of pulcherrimin pigment produced by Metschnikowia pulcherrima against various yeast species. J Microbiol Biotechnol Food Sci. 2015;5:282–285. doi: 10.15414/jmbfs.2015/16.5.3.282-285. [DOI] [Google Scholar]
- Kawulka K, Sprules T, McKay RT, Mercier P, Diaper CM, Zuber P, Vederas JC. Structure of subtilosin A, an antimicrobial peptide from Bacillus subtilis with unusual posttranslational modifications linking cysteine sulfurs to α-carbons of phenylalanine and threonine. J Am Chem Soc. 2003;125:4726–4727. doi: 10.1021/ja029654t. [DOI] [PubMed] [Google Scholar]
- Kenig M, Abraham EP. Antimicrobial activities and antagonists of bacilysin and anticapsin. J Gen Microbiol. 1976;94:37–45. doi: 10.1099/00221287-94-1-37/CITE/REFWORKS. [DOI] [PubMed] [Google Scholar]
- Kenig M, Vandamme E, Abraham EP. The mode of action of bacilysin and anticapsin and biochemical properties of bacilysin resistant mutants. J Gen Microbiol. 1976;94:46–54. doi: 10.1099/00221287-94-1-46. [DOI] [PubMed] [Google Scholar]
- Khan MA, Göpel Y, Milewski S, Görke B. Two small RNAs conserved in enterobacteriaceae provide intrinsic resistance to antibiotics targeting the cell wall biosynthesis enzyme glucosamine-6-phosphate synthase. Front Microbiol. 2016;7:908. doi: 10.3389/FMICB.2016.00908/BIBTEX. [DOI] [PMC free article] [PubMed] [Google Scholar]
- Kumar V, Hainaut M, Delhomme N, Mannapperuma C, Immerzeel P, Street NR, Henrissat B, Mellerowicz EJ. Poplar carbohydrate-active enzymes: whole-genome annotation and functional analyses based on RNA expression data. Plant J. 2019;99:589–609. doi: 10.1111/TPJ.14417. [DOI] [PMC free article] [PubMed] [Google Scholar]
- Lee H, Churey JJ, Worobo RW. Purification and structural characterization of bacillomycin F produced by a bacterial honey isolate active against Byssochlamysfulva H25. J Appl Microbiol. 2008;105:663–673. doi: 10.1111/J.1365-2672.2008.03797.X. [DOI] [PubMed] [Google Scholar]
- Lee H, Churey JJ, Worobo RW. Antimicrobial activity of bacterial isolates from different floral sources of honey. Int J Food Microbiol. 2008;126:240–244. doi: 10.1016/J.IJFOODMICRO.2008.04.030. [DOI] [PubMed] [Google Scholar]
- Lee I, Kim YO, Park SC, Chun J. OrthoANI: an improved algorithm and software for calculating average nucleotide identity. Int J Syst Evol Microbiol. 2016;66:1100–1103. doi: 10.1099/ijsem.0.000760. [DOI] [PubMed] [Google Scholar]
- Lee HT, Lee CC, Yang JR, Lai JZC, Chang KY, Ray O (2015) A large-scale structural classification of antimicrobial peptides. Biomed Res Int 2015 10.1155/2015/475062 [DOI] [PMC free article] [PubMed]
- Lefort V, Desper R, Gascuel O. FastME 2.0: a comprehensive, accurate, and fast distance-based phylogeny inference program. Mol Biol Evol. 2015;32:2798–2800. doi: 10.1093/MOLBEV/MSV150. [DOI] [PMC free article] [PubMed] [Google Scholar]
- Letunic I, Bork P. Interactive Tree Of Life (iTOL) v5: an online tool for phylogenetic tree display and annotation. Nucleic Acids Res. 2021;49:W293–W296. doi: 10.1093/NAR/GKAB301. [DOI] [PMC free article] [PubMed] [Google Scholar]
- Li G, Liu B, Shang Y, Yu Z, Zhang R. Novel activity evaluation and subsequent partial purification of antimicrobial peptides produced by Bacillus subtilis LFB112. Ann Microbiol. 2012;62:667–674. doi: 10.1007/s13213-011-0303-9. [DOI] [Google Scholar]
- Luo C, Chen M, Luo K, Yin X, Onchari MM, Wang X, Zhang J, Zhong H, Tian B (2023) Genome sequencing and genetic engineering reveal the contribution of bacitracin produced by Bacillus paralicheniformis CPL618 to anti-Staphylococcus aureus activity. Curr Microbiol 80 10.1007/S00284-023-03196-1 [DOI] [PubMed]
- Magno-Perez-Bryan MC, Martinez-Garcia PM, Hierrezuelo J, Rodriguez-Palenzuela P, Arrebola E, Ramos C, De Vicente A, Perez-Garcia A, Romero D. Comparative genomics within the bacillus genus reveal the singularities of two robust bacillus amyloliquefaciens biocontrol strains. Mol Plant-Microbe Interact. 2015;28:1102–1116. doi: 10.1094/MPMI-02-15-0023-R. [DOI] [PubMed] [Google Scholar]
- Majtan J, Bucekova M, Kafantaris I, Szweda P, Hammer K, Mossialos D. Honey antibacterial activity: a neglected aspect of honey quality assurance as functional food. Trends Food Sci Technol. 2021;118:870–886. doi: 10.1016/J.TIFS.2021.11.012. [DOI] [Google Scholar]
- May JJ, Wendrich TM, Marahiel MA. The dhb operon of Bacillus subtilis encodes the biosynthetic template for the catecholic siderophore 2,3-dihydroxybenzoate-glycine-threonine trimeric ester bacillibactin. J Biol Chem. 2001;276:7209–7217. doi: 10.1074/jbc.M009140200. [DOI] [PubMed] [Google Scholar]
- Mayerl F, Fisher S, Pirnik D, Aklonis C, Dean L, Meyers E, Fernandes P. Bacillaene, a novel inhibitor of procaryotic protein synthesis produced by Bacillus subtilis: production, taxonomy, isolation, physico-chemical characterization and biological activity. J Antibiot (tokyo) 1995;48:997–1003. doi: 10.7164/ANTIBIOTICS.48.997. [DOI] [PubMed] [Google Scholar]
- Meier-Kolthoff JP. Göker M (2019) TYGS is an automated high-throughput platform for state-of-the-art genome-based taxonomy. Nat Commun. 2019;101(10):1–10. doi: 10.1038/s41467-019-10210-3. [DOI] [PMC free article] [PubMed] [Google Scholar]
- Ming LJ, Epperson JD. Metal binding and structure–activity relationship of the metalloantibiotic peptide bacitracin. J Inorg Biochem. 2002;91:46–58. doi: 10.1016/S0162-0134(02)00464-6. [DOI] [PubMed] [Google Scholar]
- Molan PC (2015) The antibacterial activity of honey. 101080/0005772X199211099109 73:5–28. https://doi.org/10.1080/0005772X.1992.11099109
- Moniruzzaman M, Khalil MI, Sulaiman SA, Gan SH (2011) Advances in the analytical methods for determining the antioxidant properties of honey: a review. African J Tradit Complement Altern Med AJTCAM 9 10.4314/AJTCAM.V9I1.5 [DOI] [PMC free article] [PubMed]
- Motta AS, Flores FS, Souto AA, Brandelli A. Antibacterial activity of a bacteriocin-like substance produced by Bacillus sp. P34 that targets the bacterial cell envelope Antonie Van Leeuwenhoek. Int J Gen Mol Microbiol. 2008;93:275–284. doi: 10.1007/S10482-007-9202-2/FIGURES/6. [DOI] [PubMed] [Google Scholar]
- Mundo MA, Padilla-Zakour OI, Worobo RW. Growth inhibition of foodborne pathogens and food spoilage organisms by select raw honeys. Int J Food Microbiol. 2004;97:1–8. doi: 10.1016/J.IJFOODMICRO.2004.03.025. [DOI] [PubMed] [Google Scholar]
- Nandy SK, Bapat PM, Venkatesh KV. Sporulating bacteria prefers predation to cannibalism in mixed cultures. FEBS Lett. 2007;581:151–156. doi: 10.1016/J.FEBSLET.2006.12.011. [DOI] [PubMed] [Google Scholar]
- Nannan C, Vu HQ, Gillis A, Caulier S, Nguyen TTT, Mahillon J. Bacilysin within the Bacillus subtilis group: gene prevalence versus antagonistic activity against Gram-negative foodborne pathogens. J Biotechnol. 2021;327:28–35. doi: 10.1016/J.JBIOTEC.2020.12.017. [DOI] [PubMed] [Google Scholar]
- Newman DJ, Cragg GM. Natural products as sources of new drugs over the last 25 years. J Nat Prod. 2007;70:461–477. doi: 10.1021/np068054v. [DOI] [PubMed] [Google Scholar]
- Ongena M, Jacques P. Bacillus lipopeptides: versatile weapons for plant disease biocontrol. Trends Microbiol. 2008;16:115–125. doi: 10.1016/J.TIM.2007.12.009. [DOI] [PubMed] [Google Scholar]
- Pajor M, Worobo RW, Milewski S, Szweda P (2018) The antimicrobial potential of bacteria isolated from honey samples produced in the apiaries located in pomeranian voivodeship in Northern Poland. Int J Environ Res Public Health 15 10.3390/IJERPH15092002 [DOI] [PMC free article] [PubMed]
- Pajor M, Xiong ZR, Worobo RW, Szweda P (2020) Paenibacillus alvei mp1 as a producer of the proteinaceous compound with activity against important human pathogens, including staphylococcus aureus and listeria monocytogenes. Pathogens 9 10.3390/pathogens9050319 [DOI] [PMC free article] [PubMed]
- Pasupuleti VR, Sammugam L, Ramesh N, Gan SH (2017) Honey, propolis, and royal jelly: a comprehensive review of their biological actions and health benefits. Oxid Med Cell Longev 2017 10.1155/2017/1259510 [DOI] [PMC free article] [PubMed]
- Pavlova AS, Ozhegov GD, Arapidi GP, Butenko IO, Fomin ES, Alemasov NA, Afonnikov DA, Yarullina DR, Ivanov VT, Govorun VM, Kayumov AR. Identification of antimicrobial peptides from novel Lactobacillus fermentum strain. Protein J. 2020;39:73–84. doi: 10.1007/S10930-019-09879-8. [DOI] [PubMed] [Google Scholar]
- Pełka K, Otłowska O, Worobo RW, Szweda P. Bee bread exhibits higher antimicrobial potential compared to bee pollen. Antibiot (basel, Switzerland) 2021;10:1–14. doi: 10.3390/ANTIBIOTICS10020125. [DOI] [PMC free article] [PubMed] [Google Scholar]
- Pełka K, Worobo RW, Walkusz J, Szweda P (2021b) Bee pollen and bee bread as a source of bacteria producing antimicrobials. Antibiot (Basel, Switzerland) 10 10.3390/ANTIBIOTICS10060713 [DOI] [PMC free article] [PubMed]
- Placzek S, Schomburg I, Chang A, Jeske L, Ulbrich M, Tillack J, Schomburg D. BRENDA in 2017: new perspectives and new tools in BRENDA. Nucleic Acids Res. 2017;45:D380–D388. doi: 10.1093/NAR/GKW952. [DOI] [PMC free article] [PubMed] [Google Scholar]
- Richter M, Rosselló-Móra R. Shifting the genomic gold standard for the prokaryotic species definition. Proc Natl Acad Sci U S A. 2009;106:19126–19131. doi: 10.1073/PNAS.0906412106. [DOI] [PMC free article] [PubMed] [Google Scholar]
- Ronquist F, Teslenko M, Van Der Mark P, Ayres DL, Darling A, Höhna S, Larget B, Liu L, Suchard MA, Huelsenbeck JP. MrBayes 3.2: efficient Bayesian phylogenetic inference and model choice across a large model space. Syst Biol. 2012;61:539–542. doi: 10.1093/SYSBIO/SYS029. [DOI] [PMC free article] [PubMed] [Google Scholar]
- Ruiz A, Pinazo A, Pérez L, Manresa A, Marqués AM. Green catanionic gemini surfactant-lichenysin mixture: improved surface, antimicrobial, and physiological properties. ACS Appl Mater Interfaces. 2017;9:22121–22131. doi: 10.1021/acsami.7b03348. [DOI] [PubMed] [Google Scholar]
- Sabaté DC, Audisio MC. Inhibitory activity of surfactin, produced by different Bacillus subtilis subsp. subtilis strains, against Listeria monocytogenes sensitive and bacteriocin-resistant strains. Microbiol Res. 2013;168:125–129. doi: 10.1016/J.MICRES.2012.11.004. [DOI] [PubMed] [Google Scholar]
- Schnürer J, Magnusson J. Antifungal lactic acid bacteria as biopreservatives. Trends Food Sci Technol. 2005;16:70–78. doi: 10.1016/J.TIFS.2004.02.014. [DOI] [Google Scholar]
- Seemann T. Prokka: rapid prokaryotic genome annotation. Bioinformatics. 2014;30:2068–2069. doi: 10.1093/BIOINFORMATICS/BTU153. [DOI] [PubMed] [Google Scholar]
- Shelburne CE, An FY, Dholpe V, Ramamoorthy A, Lopatin DE, Lantz MS. The spectrum of antimicrobial activity of the bacteriocin subtilosin A. J Antimicrob Chemother. 2007;59:297–300. doi: 10.1093/JAC/DKL495. [DOI] [PubMed] [Google Scholar]
- Snowdon JA, Cliver DO. Microorganisms in honey. Int J Food Microbiol. 1996;31:1–26. doi: 10.1016/0168-1605(96)00970-1. [DOI] [PubMed] [Google Scholar]
- Song W, Sun HX, Zhang C, Cheng L, Peng Y, Deng Z, Wang D, Wang Y, Hu M, Liu W, Yang H, Shen Y, Li J, You L, Xiao M. Prophage Hunter: an integrative hunting tool for active prophages. Nucleic Acids Res. 2019;47:W74–W80. doi: 10.1093/NAR/GKZ380. [DOI] [PMC free article] [PubMed] [Google Scholar]
- Straight PD, Fischbach MA, Walsh CT, Rudner DZ, Kolter R. A singular enzymatic megacomplex from Bacillus subtilis. Proc Natl Acad Sci U S A. 2007;104:305–310. doi: 10.1073/pnas.0609073103. [DOI] [PMC free article] [PubMed] [Google Scholar]
- Sumi CD, Yang BW, Yeo IC, Hahm YT. Antimicrobial peptides of the genus Bacillus: a new era for antibiotics. Can J Microbiol. 2015;61:93–103. doi: 10.1139/CJM-2014-0613/ASSET/IMAGES/CJM-2014-0613TAB2.GIF. [DOI] [PubMed] [Google Scholar]
- Sutyak KE, Wirawan RE, Aroutcheva AA, Chikindas ML. Isolation of the Bacillus subtilis antimicrobial peptide subtilosin from the dairy product-derived Bacillus amyloliquefaciens. J Appl Microbiol. 2008;104:1067–1074. doi: 10.1111/J.1365-2672.2007.03626.X. [DOI] [PMC free article] [PubMed] [Google Scholar]
- Tatusova T, Dicuccio M, Badretdin A, Chetvernin V, Nawrocki EP, Zaslavsky L, Lomsadze A, Pruitt KD, Borodovsky M, Ostell J. NCBI prokaryotic genome annotation pipeline. Nucleic Acids Res. 2016;44:6614–6624. doi: 10.1093/NAR/GKW569. [DOI] [PMC free article] [PubMed] [Google Scholar]
- Tay WM, Epperson JD, Da Silva GFZ, Ming LJ. 1H NMR, mechanism, and mononuclear oxidative activity of the antibiotic metallopeptide bacitracin: the role of d -Glu-4, interaction with pyrophosphate moiety, DNA binding and cleavage, and bioactivity. J Am Chem Soc. 2010;132:5652–5661. doi: 10.1021/ja910504t. [DOI] [PubMed] [Google Scholar]
- Thiruvengadam R, Gandhi K, Vaithiyanathan S, Sankarasubramanian H, Loganathan K, Lingan R, Rajagopalan VR, Muthurajan R, Ebenezer Iyadurai J, Kuppusami P. Complete genome sequence analysis of Bacillus subtilis Bbv57, a promising biocontrol agent against phytopathogens. Int J Mol Sci. 2022;23:9732–23:9732. doi: 10.3390/IJMS23179732. [DOI] [PMC free article] [PubMed] [Google Scholar]
- Torrent M, Di Tommaso P, Pulido D, Nogués MV, Notredame C, Boix E, Andreu D. AMPA: an automated web server for prediction of protein antimicrobial regions. Bioinformatics. 2012;28:130–131. doi: 10.1093/BIOINFORMATICS/BTR604. [DOI] [PubMed] [Google Scholar]
- Torres-Sánchez A, Pardo-Cacho J, López-Moreno A, Ruiz-Moreno Á, Cerk K, Aguilera M. Antimicrobial effects of potential probiotics of Bacillus spp. isolated from human microbiota: in vitro and in silico methods. Microorg. 2021;9:1615–9:1615. doi: 10.3390/MICROORGANISMS9081615. [DOI] [PMC free article] [PubMed] [Google Scholar]
- Van Heel AJ, De Jong A, Song C, Viel JH, Kok J, Kuipers OP. BAGEL4: a user-friendly web server to thoroughly mine RiPPs and bacteriocins. Nucleic Acids Res. 2018;46:W278–W281. doi: 10.1093/nar/gky383. [DOI] [PMC free article] [PubMed] [Google Scholar]
- Van Staden ADP, Heunis T, Smith C, Deane S, Dicks LMT. Efficacy of lantibiotic treatment of Staphylococcus aureus-induced skin infections, monitored by in vivo bioluminescent imaging. Antimicrob Agents Chemother. 2016;60:3948–3955. doi: 10.1128/AAC.02938-15. [DOI] [PMC free article] [PubMed] [Google Scholar]
- Vater J, Kablitz B, Wilde C, Franke P, Mehta N, Cameotra SS. Matrix-assisted laser desorption ionization-time of flight mass spectrometry of lipopeptide biosurfactants in whole cells and culture filtrates of Bacillus subtilis C-1 isolated from petroleum sludge. Appl Environ Microbiol. 2002;68:6210–6219. doi: 10.1128/AEM.68.12.6210-6219.2002. [DOI] [PMC free article] [PubMed] [Google Scholar]
- Waddington KD. Bees and beekeeping: science, practice and world resources. Eva Crane Q Rev Biol. 1991;66:498–499. doi: 10.1086/417380. [DOI] [Google Scholar]
- Wadi MA (2022) In vitro antibacterial activity of different honey samples against clinical isolates. Biomed Res Int 2022 10.1155/2022/1560050 [DOI] [PMC free article] [PubMed]
- Waghu FH, Barai RS, Gurung P, Idicula-Thomas S. CAMPR3: a database on sequences, structures and signatures of antimicrobial peptides. Nucleic Acids Res. 2016;44:D1094–D1097. doi: 10.1093/nar/gkv1051. [DOI] [PMC free article] [PubMed] [Google Scholar]
- Weinberg ED (1967) Bacitracin, gramicidin and tyrocidine. Biosynthesis 240–253 10.1007/978-3-662-38441-1_21
- Wick RR, Judd LM, Gorrie CL, Holt KE. Unicycler: resolving bacterial genome assemblies from short and long sequencing reads. PLOS Comput Biol. 2017;13:e1005595. doi: 10.1371/JOURNAL.PCBI.1005595. [DOI] [PMC free article] [PubMed] [Google Scholar]
- Xiong ZR, Cobo M, Whittal RM, Snyder AB, Worobo RW. Purification and characterization of antifungal lipopeptide produced by Bacillus velezensis isolated from raw honey. PLoS One. 2022;17:e0266470. doi: 10.1371/journal.pone.0266470. [DOI] [PMC free article] [PubMed] [Google Scholar]
- Yang YL, Xu Y, Straight P. Dorrestein PC (2009) Translating metabolic exchange with imaging mass spectrometry. Nat Chem Biol. 2009;512(5):885–887. doi: 10.1038/nchembio.252. [DOI] [PMC free article] [PubMed] [Google Scholar]
- Yang H, Li X, Li X, Yu H, Shen Z. Identification of lipopeptide isoforms by MALDI-TOF-MS/MS based on the simultaneous purification of iturin, fengycin, and surfactin by RP-HPLC. Anal Bioanal Chem. 2015;407:2529–2542. doi: 10.1007/S00216-015-8486-8/TABLES/1. [DOI] [PubMed] [Google Scholar]
- Yin H, Guo C, Wang Y, Liu D, Lv Y, Lv F, Lu Z. Fengycin inhibits the growth of the human lung cancer cell line 95D through reactive oxygen species production and mitochondria-dependent apoptosis. Anticancer Drugs. 2013;24:587–598. doi: 10.1097/CAD.0B013E3283611395. [DOI] [PubMed] [Google Scholar]
- Zacharof MP, Lovitt RW. Bacteriocins produced by lactic acid bacteria a review article. APCBEE Proc. 2012;2:50–56. doi: 10.1016/J.APCBEE.2012.06.010. [DOI] [Google Scholar]
- Zhang H, Yohe T, Huang L, Entwistle S, Wu P, Yang Z, Busk PK, Xu Y, Yin Y. dbCAN2: a meta server for automated carbohydrate-active enzyme annotation. Nucleic Acids Res. 2018;46:W95–W101. doi: 10.1093/NAR/GKY418. [DOI] [PMC free article] [PubMed] [Google Scholar]
Associated Data
This section collects any data citations, data availability statements, or supplementary materials included in this article.
Supplementary Materials
Data Availability Statement
The data presented in this study are available on request from the corresponding author.